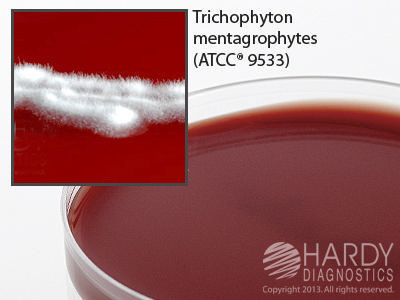

Liver Infusion Agar Selective Plate , Pack Of 10
$ 71.48
|
|
Details:
Liver Infusion Agar Selective, 15x100mm plate r pk10^
Additional Information
| SKU | 23511449 |
|---|---|
| UOM | Pack of 10 |
| UNSPSC | 41106200 |
| Manufacturer Part Number | W95 |
| Product Dimensions | 4X4X8 Inches |
| Product Weight | 1 |
